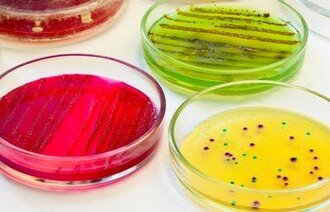

Antibiotika eller ikke antibiotika?

Jørgen Bjørnholt, overlege ved Folkehelseinstituttet sier at metenamin er registrert som antibiotika, men egentlig er et antiseptikum.
- Dette burde kommet tydligere frem i rapporten etter prevalensundersøkelsen, sier han.
Onsdag fortalte Sykepleien at en ny undersøkelse ifølge Folkehelseinstituttet viser utstrakt bruk av antibiotika for å forebygge urinveisinfeksjoner.
I en rapport etter prevalensundersøkelsen hvor halvparten av landets sykehjem har deltatt, heter det:
«Det antibiotikum (virkestoff) som ble mest brukt var metenamin (Hiprex), men også trimetoprim og nitrofuratoin ble benyttet til å forebygge urinveisinfeksjoner.».
I rapporten heter det videre:
«Vårens undersøkelse viser en utstrakt bruk av antibiotika for å forebygge urinveisinfeksjoner».
Observante lesere har reagert på at metenamin, det mest brukte middelet, blir klassifisert som et antibiotikum, ikke antiseptikum.
Klassifiseres sammen med antibiotika
Spørsmålet går derfor tilbake til overlege Jørgen Bjørnholt ved Folkehelseinstituttet, som forklarer:
- Det er helt korrekt at metenamin er et antiseptikum.
- Legemiddelepidemiologer klassifiserer metenamin sammen med antibiotika under J01, ATC kode; «Antibakterielle midler til systemisk bruk». Det er denne klassifiseringen en bruker når en lager legemiddelstatistikk, sier han.
Han sier at metenamin omdannes i sur urin til formaldehyd i løpet av en times tid, derfor skal det ikke brukes av pasienter som har kateter eller basisk urin.
- Hvorfor velger dere å ta med dette i statistikken over antibiotikabruk?
- Metenamin er et antibakterielt middel til systemisk bruk som har klare begrensninger for sin anvendelse. Likevel brukes det i Norge 2,5 ganger mer per innbygger enn for eksempel Sverige. Det er derfor god grunn til å se nærmere på bruken i Norge, sier Bjørnholt.
- Burde kommet tydligere frem i rapporten
- Men selv om det er klassifisert som et antibiotikum, er det altså ikke et antibiotikum?
- Metenamin er et antiseptikum, men i legemiddelstatistikk blir er det klassifisert sammen med antibiotika i ATC gruppe J01: Antibakterielle midler til systemisk bruk. Det burde ha kommet tydeligere frem i rapporten, sier han.
- Hvis dere trekker fra dette middelet i tallene som viser antibiotikabruken ved norske sykehjem, står dere fremdeles inne for det som det konkluderes med i rapporten: At det er «en utstrakt bruk av antibiotika for å forebygge urinveisinfeksjoner i sykehjem?»
- En må som nevnt være forsiktig med å konkludere ut fra denne type undersøkelser. De gir kun et øyeblikksbilde, og konklusjonen må ikke tas ut av sin sammenheng. Knapt 25 prosent av beboere som fikk forebyggende behandling mot urinveisinfeksjon, fikk antibiotika. Det er grunn til å se nærmere på bruken av både antibiotika og antiseptika, sier Bjørnholt.
Ønsker diskusjon
Dag Berild er overlege ved Oslo Universitetssykehus. Han forsker på infeksjonssykdommer, og sitter i Folkehelseinstituttets antibiotikagruppe.
Når han blir oppringt med spørsmålet om han synes det er riktig å kategorisere metenamin som et antibiotikum i statistikken over antibiotikabruk ved norske sykehjem, blir han usikker:
- Jeg vet ikke hvilket standpunkt jeg skal ta til definisjonen av metenamin som antibiotikum. Metenamin i seg selv dreper ikke bakterier. Først må urinen surgjøres.
Men han er glad for at bruken nå blir diskutert og sett nærmere på:
- For å si det slik: Jeg er veldig glad for at bruken av dette middelet blir diskutert. Det er sparsom evidens for at det virker forebyggende på urinveisinfeksjoner, og det brukes mye i Norge.
- De fleste regner det som et antibiotikum, men det brukes ikke til behandling, derfor har vi ikke viet det særlig oppmerksomhet, sier han.
- Når det gjelder resistens, er jeg blank. Jeg har ikke sett norske data på dette. Samtidig vil jeg si at effekten ved bruk ikke er overbevisende, så jeg er enig i at det er god grunn til å se nærmere på både retningslinjer og bruk.
- Hemmer bakterievekst
Berild utdyper:
- Methenamin (Hiprex) har virkning på bakterier ved at det spaltes til formaldehyd i urinen, Det er formaldehyd som påvirker bakteriene. For at det skal drepe bakterien må visse forutsetninger være oppfylt:
1. Konsentrasjonen av formaldehyd i blæren må være ganske høy
2. pH i blæren bør være sur, helst ned mot 5,5. Dette kan være vanskelig å oppnå.
3. Antibakteriell virkning er avhengig av at virkestoffet er i blæren i minst 1-2 timer. Det er derfor Hiprex ikke virker på pasienter med blærekatere, fordi transittiden i blæren er for kort, sier han.
Hiprex brukes hovedsakelig i Norge og Sverige, og evidensen for virkning er svak, sier han og viser til en Cochrane-review.
- Det er ingen tvil om at det mangler studier av høy kvalitet på forskjellige pasientpopulajoner for endelig å kunne si noe om Hiprex-effekt. Studier som er omtalt i Cochrane-oversikten er av lav kvalitet.
- Men, hvis man først skal overforbruke et antibiotikum, er ikke dette det verste fordi det ikke brukes til behandling av akutte urinveisinfeksjoner, sier Berild.
- Så du mener altså det er et antibiotikum?
- Ja, sier han etter å ha fått tid til å tenke over det.
- Det må etter mitt skjønn defineres som et antibiotikum fordi dets splittprodukt hemmer bakterievekst, sier han.
- Er ikke antibiotikum
Meda er Legemiddelfirmaet som selger Hiprex i Norge. Produktsjef Cecilie Østberg Calisch har følgende kommentar:
- Hiprex er ikke et antibiotikum, men et urinveisantiseptikum. Mikrober kan derfor ikke utvikle resistens mot Hiprex. Legemiddelet brukes for å forbygge kronisk residiverende urinveisinfeksjoner. En av fordelen med å forebygge residiverende urinveisinfeksjoner med Hiprex er at antibiokabruken kan reduseres.
- Dersom sykehjemsbeboerne bruker kateter, noe undersøkelsen ikke sier noe om, er det ikke gode nok data på forebygging av kateterrelaterte urinveisinfeksjoner ved bruk at Hiprex, er hennes kommentar.
Dette skriver Norsk Legemiddelhåndbok om metenamin.
LES OGSÅ:
Riktig stell kan forebygge urinveisinfeksjoner
Forebygger antiseptisk væske urinveisinfeksjon ved innleggelse av permanent urinkateter?
Forebygging av urinveisinfeksjoner i sykehjem

0 Kommentarer